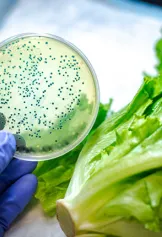
Testing lettuce in a lab

Events
Keller and Heckman hosts numerous seminars and webinars for the industries they serve. In addition to being recognized as leaders in their field, the attorneys and scientists are frequently invited to speak at industry conferences.
Filter Keller and Heckman Events
Your search returned no results. Try searching again with fewer filters or less specific terms.
Filter Upcoming Speaking Engagements
Your search returned no results. Try searching again with fewer filters or less specific terms.
Filter Past Events
Partner Art Garrett to Present at a myLawCLE Program on Insurance Coverage for Food Contamination and Recalls Incidents
Speaking Engagement
12.11.2025
Partners Art Garrett and Eve Pelonis to Present in IRMI Food Recall Webinar
Speaking Engagement
04.23.2024